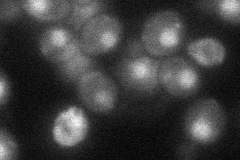
YDR121W

View description
Shared subunit of DNA polymerase (II) epsilon and of ISW2/yCHRAC chromatin accessibility complex; involved in both chromosomal DNA replication and in inheritance of telomeric silencing
Localization:
Intensity:
Fold change:
Significance:
-
C’ GFP library in SD

below threshold15.97 -
N' NOP1pr-GFP in SD

cytosol,nucleus100.989 -
N' TEF2pr-mCherry in SD

cytosol,nucleus119.38 -
N' NATIVEpr-GFP in SD

nucleus64.0908 -
N' TEF2pr-VC and Cyto-VN in SD
nucleus35.7387 -
C’ GFP library in SD+DTT

cytosol16.331.02No -
C’ GFP library in SD+H2O2

cytosol15.460.96No -
C’ GFP library in Starvation Media

cytosol16.951.06No -
C’ GFP library on the background of Pup2-DaMP

below threshold -
C’ GFP library on the background of CCT mutant

below thresholdN/AN/ANo
